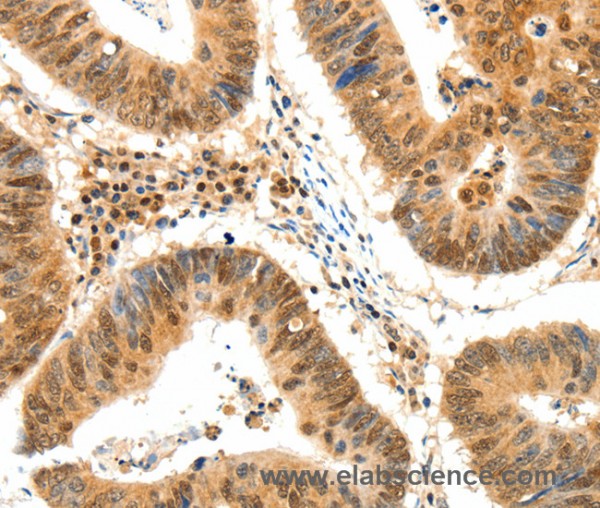
Anti-TERF2

Cookie preferences
This website uses cookies, which are necessary for the technical operation of the website and are always set. Other cookies, which increase the comfort when using this website, are used for direct advertising or to facilitate interaction with other websites and social networks, are only set with your consent.
Configuration
Technically required
These cookies are necessary for the basic functions of the shop.
"Allow all cookies" cookie
"Decline all cookies" cookie
CSRF token
Cookie preferences
Currency change
Customer-specific caching
FACT-Finder tracking
Individual prices
Selected shop
Session
Comfort functions
These cookies are used to make the shopping experience even more appealing, for example for the recognition of the visitor.
Note
Show the facebook fanpage in the right blod sidebar
Statistics & Tracking
Affiliate program
Conversion and usertracking via Google Tag Manager
Track device being used
If you have any questions, please use our Contact Form.
You can also order by e-mail: info@biomol.com
Larger quantity required? Request bulk
You can also order by e-mail: info@biomol.com
Larger quantity required? Request bulk
This gene encodes a telomere specific protein, TERF2, which is a component of the telomere... more
Product information "Anti-TERF2"
This gene encodes a telomere specific protein, TERF2, which is a component of the telomere nucleoprotein complex. This protein is present at telomeres in metaphase of the cell cycle, is a second negative regulator of telomere length and plays a key role in the protective activity of telomeres. While having similar telomere binding activity and domain organization, TERF2 differs from TERF1 in that its N terminus is basic rather than acidic. Protein function: Binds the telomeric double-stranded 5'-TTAGGG-3' repeat and plays a central role in telomere maintenance and protection against end-to-end fusion of chromosomes. In addition to its telomeric DNA-binding role, required to recruit a number of factors and enzymes required for telomere protection, including the shelterin complex, TERF2IP/RAP1 and DCLRE1B/Apollo. Component of the shelterin complex (telosome) that is involved in the regulation of telomere length and protection. Shelterin associates with arrays of double-stranded 5'-TTAGGG-3' repeats added by telomerase and protects chromosome ends, without its protective activity, telomeres are no longer hidden from the DNA damage surveillance and chromosome ends are inappropriately processed by DNA repair pathways. Together with DCLRE1B/Apollo, plays a key role in telomeric loop (T loop) formation by generating 3' single- stranded overhang at the leading end telomeres: T loops have been proposed to protect chromosome ends from degradation and repair. Required both to recruit DCLRE1B/Apollo to telomeres and activate the exonuclease activity of DCLRE1B/Apollo. Preferentially binds to positive supercoiled DNA. Together with DCLRE1B/Apollo, required to control the amount of DNA topoisomerase (TOP1, TOP2A and TOP2B) needed for telomere replication during fork passage and prevent aberrant telomere topology. Recruits TERF2IP/RAP1 to telomeres, thereby participating in to repressing homology- directed repair (HDR), which can affect telomere length. [The UniProt Consortium]
| Keywords: | Anti-TRBF2, Anti-TERF2, Anti-Telomeric DNA-binding protein, Anti-TTAGGG repeat-binding factor 2, Anti-Telomeric repeat-binding factor 2, TERF2 Polyclonal Antibody |
| Supplier: | Elabscience |
| Supplier-Nr: | E-AB-15871 |
Properties
| Application: | IHC, ELISA |
| Antibody Type: | Polyclonal |
| Conjugate: | No |
| Host: | Rabbit |
| Species reactivity: | human |
| Immunogen: | Synthetic peptide of human TERF2 |
| Format: | Purified |
Database Information
| KEGG ID : | K11111 | Matching products |
| UniProt ID : | Q15554 | Matching products |
| Gene ID : | GeneID 7014 | Matching products |
Handling & Safety
| Storage: | -20°C |
| Shipping: | 4°C (International: -20°C) |
Caution
Our products are for laboratory research use only: Not for administration to humans!
Our products are for laboratory research use only: Not for administration to humans!
Information about the product reference will follow.
more
You will get a certificate here
Viewed






